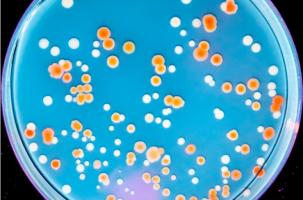
Mais comment la radiorésistance aurait-elle pu évoluer dans plusieurs organismes de notre planète, naturellement protégés du rayonnement solaire par son champ magnétique ? (Visuel Michael M. Cox and coauthors )

Vous recherchez une actualité ou un dossier
Recherche (liste)
Mode d'affichage :
-
MICROBIOTE : Le probiotique qui le protège des antibiotiques
Actualité publiée le 06/10/2021PLAIE INFECTÉE : Le patch à micro-aiguilles qui perce le biofilm
Actualité publiée le 23/09/2021
-
MÉLANOME : Les antibiotiques à l’assault des mitochondries des cellules cancéreuses
Actualité publiée le 20/08/2021ANTIBIOTIQUES : Au début de la vie, elles perturbent le développement du cerveau
Actualité publiée le 14/08/2021
-
INFECTION URINAIRE: Comment la traiter chez la personne âgée ?
Actualité publiée le 12/08/2021ANTIBIORÉSISTANCE : Ces autres médicaments courants qui la favorisent tout autant
Actualité publiée le 10/08/2021
-
CANCER COLORECTAL : Les antibiotiques facteur majeur de risque avant 50 ans
Actualité publiée le 06/07/2021C. DIFFICILE : Des récepteurs leurres pour capter les toxines
Actualité publiée le 02/07/2021
-
ANTIBIORÉSISTANCE : Sur la piste de l’hydrogène sulfuré
Actualité publiée le 24/06/2021ANTIBIORÉSISTANCE : Comment le gentil virus tue la vilaine bactérie
Actualité publiée le 17/06/2021
-
MICI : Et si la dysbiose remontait au tout début de la vie ?
Actualité publiée le 09/06/2021ANTIBIORÉSISTANCE : Elle voyage aussi
Actualité publiée le 08/06/2021
-
ANTIBIOTIQUES : Efficaces aussi pour éliminer les protéines neurotoxiques ?
Actualité publiée le 02/06/2021ARYTHMIE CARDIAQUE médicamenteuse : Le composé qui rétablit le QT
Actualité publiée le 21/05/2021
-
INFECTION CUTANÉE : Le patch microaiguilles pour délivrer ciblé
Actualité publiée le 17/05/2021ANTIBIORÉSISTANCE : Des pincettes moléculaires qui déchirent le biofilm
Actualité publiée le 16/05/2021
-
CICATRISATION : L’hydrogel qui prévient les infections résistantes des plaies
Actualité publiée le 11/05/2021ANTIBIOTIQUES au début de la vie et dermatite atopique
Actualité publiée le 08/05/2021
-
La METFORMINE protège aussi contre C. difficile
Actualité publiée le 03/05/2021ENDOCARDITE : La santé cardiaque passe par une bonne hygiène buccodentaire
Actualité publiée le 22/04/2021
-
VACCINS COVID ARNm : Premier bilan sur le risque d’allergies
Actualité publiée le 10/03/2021PHAGOTHÉRAPIE: Efficace contre Klebsiella pneumoniae pharmacorésistante
Actualité publiée le 25/02/2021
-
NUTRITION : La taurine repousse les infections bactériennes
Actualité publiée le 24/01/2021ANTIBIORÉSISTANCE : Comment ne pas se tromper de combat
Actualité publiée le 19/01/2021
-
ANTIBIORÉSISTANCE : Découvrir les protéines bactériennes clés dans l’infection
Actualité publiée le 04/01/2021COVID-19 : Des membranes de globules blancs pour transporter des médicaments
Actualité publiée le 17/12/2020
-
ANTIBIORÉSISTANCE : Le dispositif qui trahit les superbactéries
Actualité publiée le 04/12/2020ANTIBIOTIQUES : Avant l’âge de 2 ans, associés à des problèmes de santé
Actualité publiée le 17/11/2020
-
ANTIBIORÉSISTANCE : La cellule utilise des gouttes de graisse pour combattre les bactéries
Actualité publiée le 19/10/2020RADIORÉSISTANCE : Les bactéries aussi !
Actualité publiée le 01/10/2020
-
ANTIBIORÉSISTANCE : Vers de nouveaux antibactériens à spectre plus étroit
Actualité publiée le 28/09/2020PLAIES CHRONIQUES INFECTÉES : Un pansement diffuseur d'ozone
Actualité publiée le 14/09/2020
-
Les ANTIVITAMINES, les nouveaux antibiotiques?
Actualité publiée le 08/09/2020POLLUTION : Elle nourrit aussi l’antibiorésistance
Actualité publiée le 26/08/2020
Pages